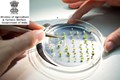
Department of Agriculture Recruitment 2022: Don’t miss the Opportunity to Become “Chief Seed Analyst”

ICAR IARI 2022: The ICAR-Indian Agricultural Research Institute or IARI, Delhi has completed the online exam process for the position of Technician Grade 1 that was held on February 28 and March 02, 04, and 05 across India. The ICAR IARI has now uploaded the answer for this exam on its official website.
Candidates who had appeared in the ICAR IARI exam can view their individual answers or online responses (Chosen answer Option & Master answer key) by logging into the official website with their registered credentials through ICAR IARI Answer Key Link.
Steps to Download ICAR IARI Answer Key 2022
Follow the steps to download and check answer key;
-
Open the official website of ICAR IARI
-
Now click on the link given for Technician Recruitment 'ICAR-IARI Post for Technician (T-1) '
-
After that login into your account
-
Finally, download ICAR IARI Answer Key
-
Check carefully
If you have any query or objection in respect of any question and its answer then you can submit your objection only through ‘Online Response Link’ in the website with documentary evidence within three days. The Objections received by the authority will be re-examined by the subject experts for its finalization.
ICAR IARI Result 2022 Update
As per officials, any information regarding the ICAR IARI result shall be notified on the official website - iari.res.in hence candidates must keep an eye on it. The result is likely to be announced this week and it would be made on the basis of objections. It must be noted that there will be no interviews for qualified applicants.
Those who qualify in the exam will have to undergo one-year on-the-job training that will be provided by the respective Institutes to the selected students.
ICAR IARI Recruitment 2022
Indian Agricultural Research Institute, Delhi had invited applications for filling up 641 vacancies for the post of Technician in December last year.